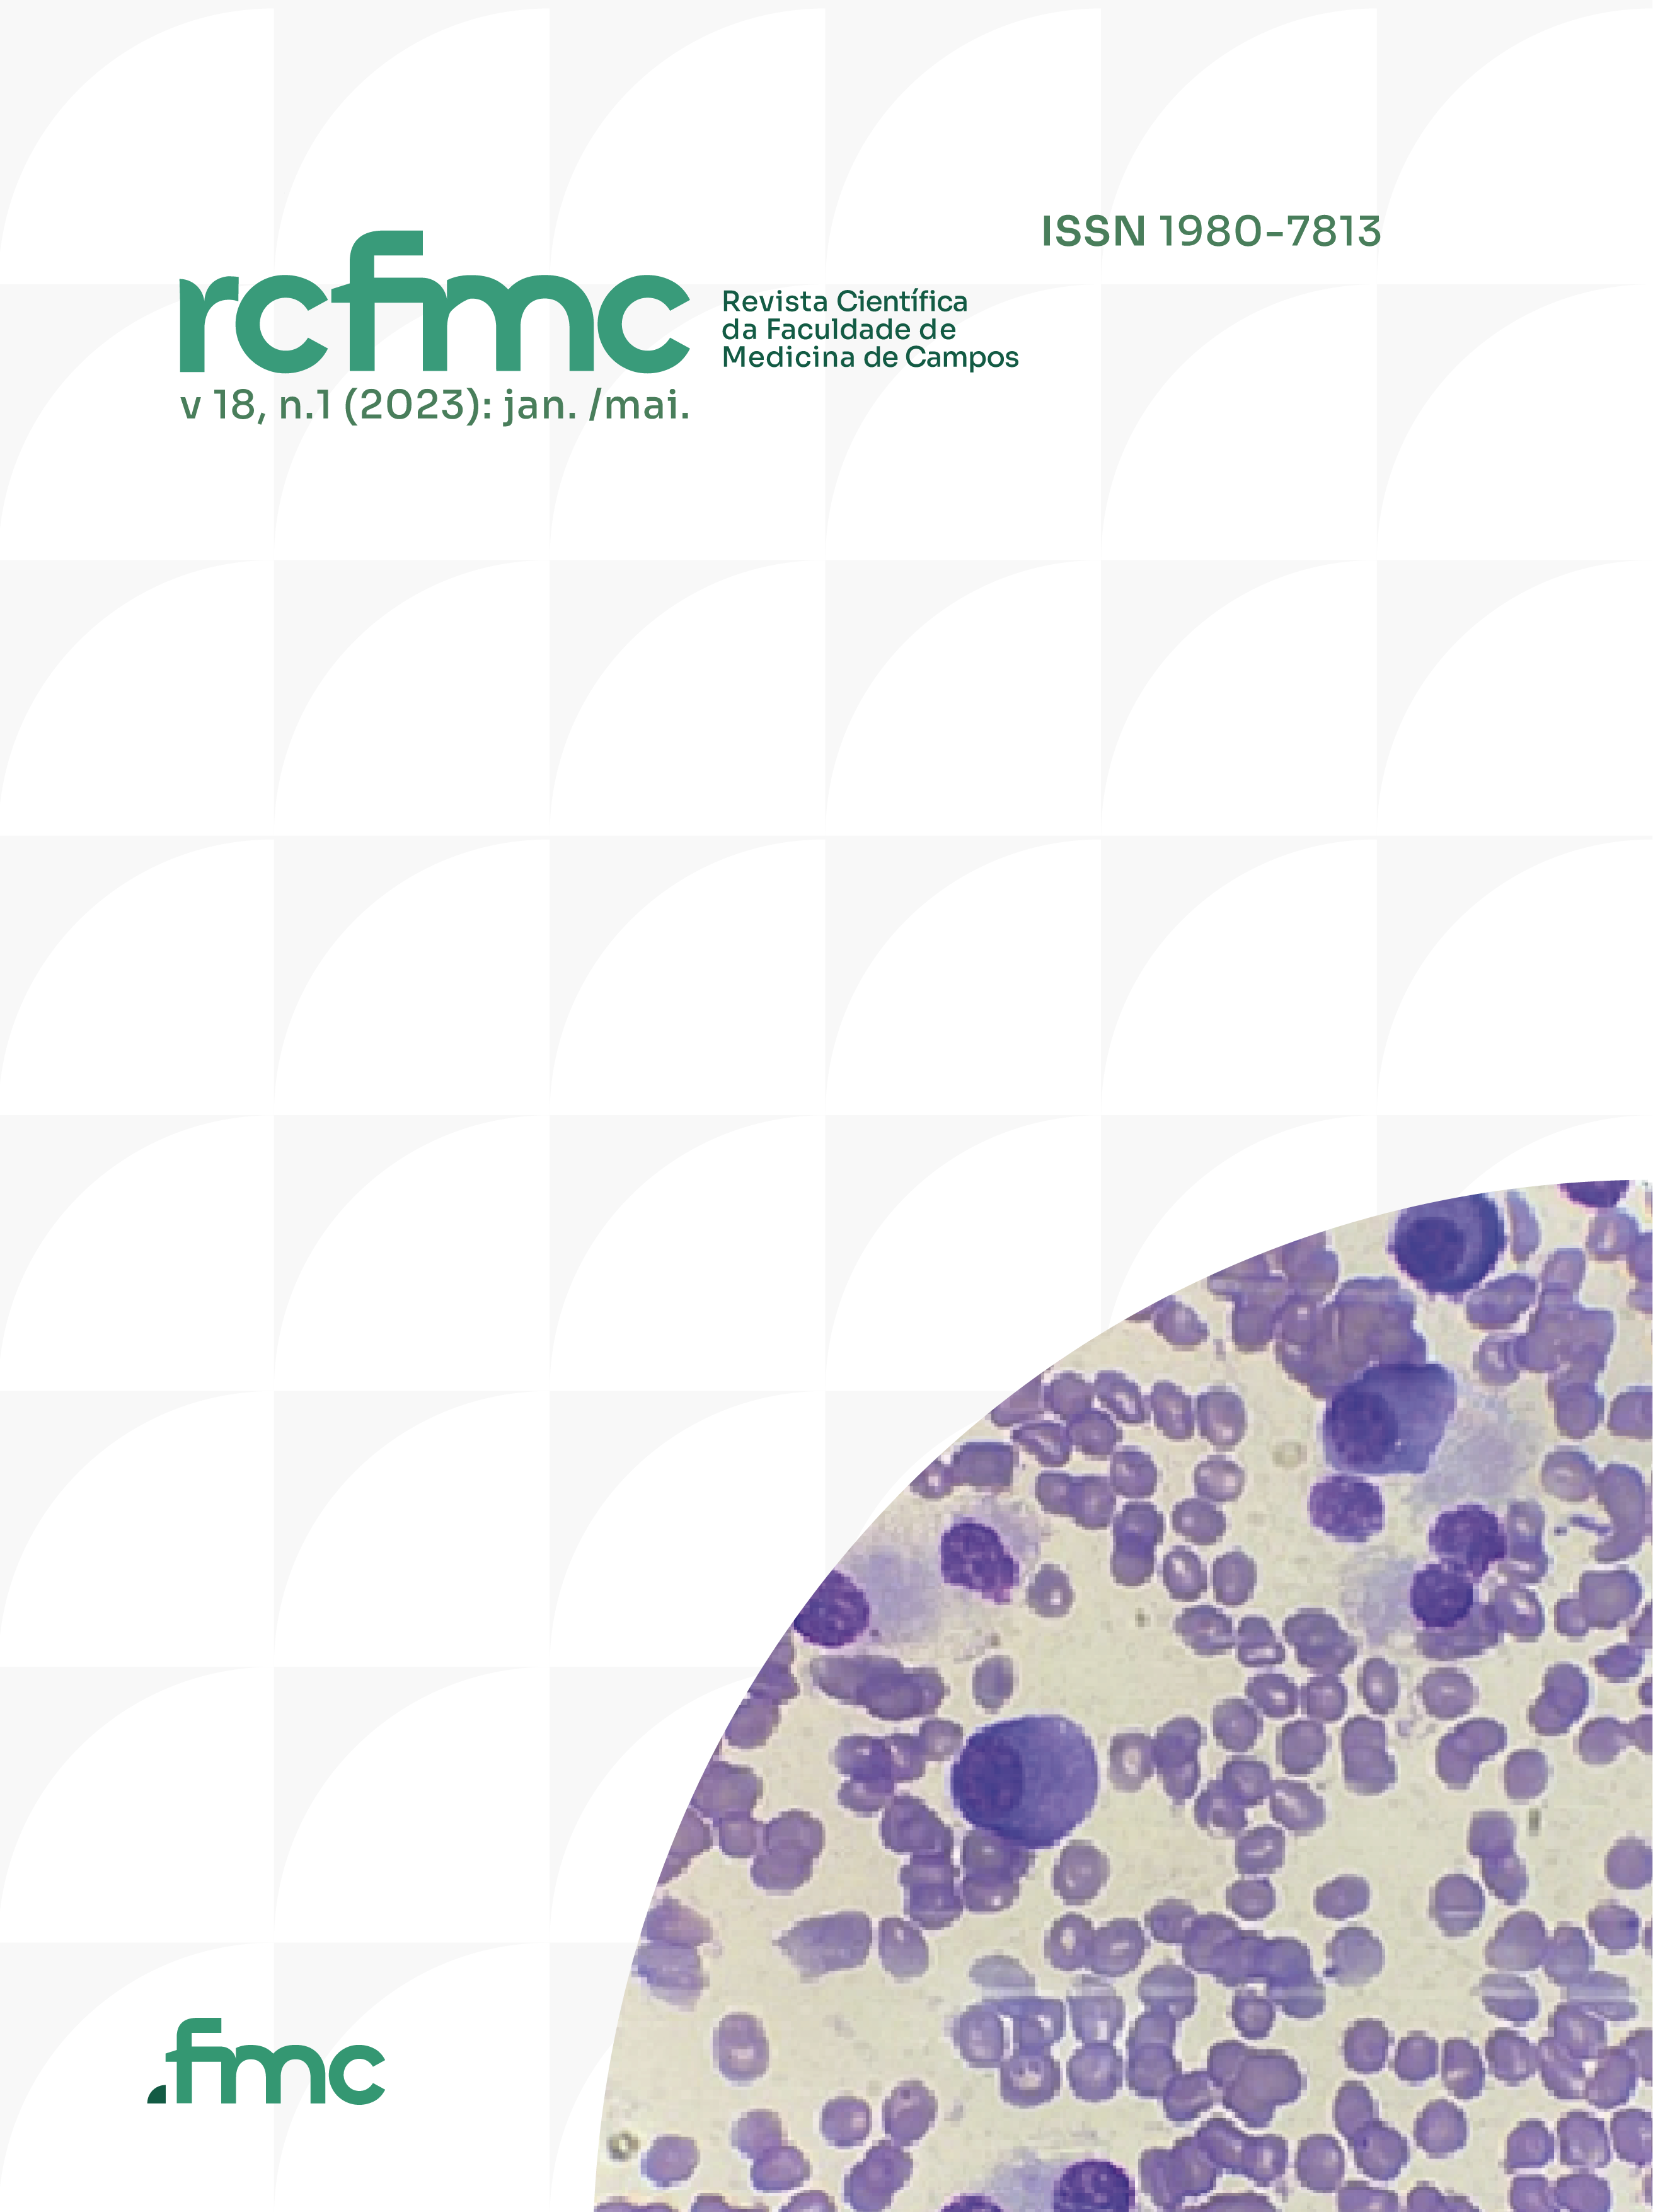

Dando continuidade à acolhida de novos alunos aprovados no Processo Seletivo 2018 (Prosel), o Campus da Universidade do Estado do Pará (Uepa) em Redenção promove a Semana do Calouro. A programação, que tem como objetivo recepcionar os estudantes, vai ocorrer a partir do dia 9 de abril, até o dia 13, durante os períodos tarde e noite.
O evento é aberto ao público e os participantes receberão certificado de presença de acordo com a assinatura na lista de frequência. A programação está sendo organizada pela Coordenação Pedagógica. Redenção é o último campus a realizar a recepção. “Resolvemos fazer agora porque estávamos esperando todas as chamadas, para poder contemplar a todos”, contou a assessora pedagógica, Rejane Goetten.
Os novos alunos vão participar de palestras, oficinas, entre outras atividades. Na abertura, dia 9 de abril, a programação vai iniciar a partir das 17h30, com a palestra As adaptações à vida universitária, ministrada pela professora do Centro de Ciências Biológicas e da Saúde (CCBS), Adriana Paiva.
Durante a semana serão apresentados os cursos do campus (Licenciatura em Ciências Naturais – Física, Engenharia de Produção, Tecnologia de Alimentos, Licenciatura Plena em Matemática) e o espaço de cada um. No último dia de programação haverá apresentações culturais e coffe break de encerramento.
Para conferir a programação completa clique aqui
Texto: Rachel Oliveira
Foto: Mácio Ferreira